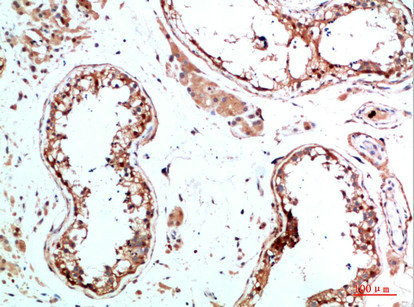

IL31 Antibody
-
中文名稱:IL31兔多克隆抗體
-
貨號:CSB-PA723018
-
規格:¥1090
-
圖片:
-
Western blot analysis of Hela Cell Lysate using antibody. Secondary antibody was diluted at 1:20000
-
Immunohistochemical analysis of paraffin-embedded human-testis, antibody was diluted at 1:200
-
Immunohistochemical analysis of paraffin-embedded human-testis, antibody was diluted at 1:200
-
Immunohistochemical analysis of paraffin-embedded human-spleen, antibody was diluted at 1:200
-
Immunohistochemical analysis of paraffin-embedded human-spleen, antibody was diluted at 1:200
-
-
其他:
產品詳情
-
Uniprot No.:
-
基因名:
-
別名:IL 31 antibody; IL-31 antibody; IL31 antibody; IL31_HUMAN antibody; Interleukin 31 antibody; Interleukin-31 antibody
-
宿主:Rabbit
-
反應種屬:Human
-
免疫原:Synthetic peptide from Human protein at AA range: 21-70
-
免疫原種屬:Homo sapiens (Human)
-
標記方式:Non-conjugated
-
純化方式:The antibody was affinity-purified from rabbit serum by affinity-chromatography using specific immunogen.
-
濃度:It differs from different batches. Please contact us to confirm it.
-
保存緩沖液:Liquid in PBS containing 50% glycerol, 0.5% BSA and 0.02% sodium azide.
-
產品提供形式:Liquid
-
應用范圍:WB,ELISA
-
推薦稀釋比:
Application Recommended Dilution WB 1:500-2000 ELISA 1:10000-20000 -
Protocols:
-
儲存條件:Upon receipt, store at -20°C or -80°C. Avoid repeated freeze.
-
貨期:Basically, we can dispatch the products out in 1-3 working days after receiving your orders. Delivery time maybe differs from different purchasing way or location, please kindly consult your local distributors for specific delivery time.
-
用途:For Research Use Only. Not for use in diagnostic or therapeutic procedures.
相關產品
靶點詳情
-
功能:Activates STAT3 and possibly STAT1 and STAT5 through the IL31 heterodimeric receptor composed of IL31RA and OSMR. May function in skin immunity. Enhances myeloid progenitor cell survival in vitro. Induces RETNLA and serum amyloid A protein expression in macrophages.
-
基因功能參考文獻:
- Eosinophils are a major source of IL-31 in bullous pemphigoid and this cytokine may contribute to itch in these patients. PMID: 29693698
- Lung cancer patients homozygous CC for rs7977932 or carried the G allele of rs4758680 had significantly poorer prognoses compared to those who did not have these genotype; the rs7977932 CC genotype was significantly associated with metastasis and poor survival status in lung adenocarcinoma PMID: 29791232
- The findings suggest that rs7977932 and rs4758680 of IL-31 may be associated with the development and progression of the epithelial ovarian cancer in the Chinese population. PMID: 29484036
- this study shows that decreased serum levels of IL-31 correlate in treated patients with Relapsing-Remitting Multiple Sclerosis PMID: 29050818
- review: in-depth overview of the role of IL-31 in chronic skin diseases and the possible diagnostic and therapeutic applications in the management of these diseases PMID: 29046191
- Obtained results, as well as literature data, show that lower concentration of IL-31 in patients' serum may be correlated with its role in JAK/STAT signaling pathway which is involved in development of autoimmune blistering disease PMID: 28808661
- IL-31 gene polymorphisms were tightly associated with dilated cardiomyopathy susceptibility and contributed to worse prognosis in DCM patients. PMID: 28572699
- This study indicated that CXCL13 rather than IL-31 may have clinical values of diagnosis and prognosis in hepatocellular carcinoma. PMID: 27663978
- The first demonstration of the involvement of the IL-31/IL-31R axis in cancer came from studies in patients with mycosis fungoides/Sezary syndrome, the most frequent, cutaneous T cell lymphoma. Tumor cells were shown to produce IL-31, whose serum levels correlated with pruritus intensity. PMID: 28408397
- IL31 and its receptor, IL31RA, are highly expressed in various human and mouse cancer cell lines, as well as in tumor specimens from cancer patients. MC38 murine colon carcinoma cells depleted of IL31 exhibit an increase in invasive and migratory properties in vitro. PMID: 28147314
- this study shows that IL-31 may be involved in the pathogenesis of asthma and rhinitis; dust mite and mugwort allergy could increase it significantly PMID: 28303765
- While serum TSLP levels were unaffected by concomitant allergies and atopic comorbidities, serum levels of IL-31, IL-33 and sST2 were affected to a small extent. We found a positive correlation between TSLP, IL-31 and IL-33, and an inverse relationship between IL-33 and sST2 PMID: 27152943
- Suggest that IL-31 gene may play a role in the development of systemic lupus erythematosus. PMID: 26769434
- High IL31 expression is associated with Endometrial Cancer. PMID: 27340318
- In a CML patient with pruritus receiving imatinib mesylate, IL-31 and IL-33 serum levels were significantly higher than controls. Imatinib could cause keratinocyte injury, the release of IL-33, and the consequent interaction with its receptor on mast cells, inducing IL-31 secretion. The IL-31/IL-33 axis may be involved in the pathogenesis of skin side effects related to imatinib mesylate treatment. PMID: 26316486
- Distinct polymorphic variants of the IL-31 gene may be involved in the patho-genesis of mastocytosis, and IL-31 may be involved in the induction of pruritus in patients with mastocytosis. PMID: 27276346
- Serum/pleural fluid IL-31 levels are elevated in tuberculous pleural effusion. PMID: 26864868
- both SCF and IL-31 play an important role in mediating inflammation and enhancing severity of atopic asthma. PMID: 26853551
- IL-31 affects keratinocyte differentiation in multiple ways and the IL-1 cytokine network is a major downstream effector of IL-31 signaling in deregulating the physical skin barrier. PMID: 26944931
- Oncostatin M and interleukin-31: Cytokines, receptors, signal transduction and physiology. PMID: 26198770
- The results of our analyses regarding serum levels and receptor expression do not suggest a central role of IL-31 in Mycosis fungoides/Sezary syndrome pathogenesis. PMID: 25488078
- In summary, TGF-beta1 and IL-31 were linked to progression from chronic hepatitis B to liver cirrhosis, and correlated well with the severity of disease. PMID: 25710085
- An increase of IL-31 serum levels in postmenopausal women with decreased bone mineral density, is shown. PMID: 26449657
- a possible systemic involvement of IL-31 and the absence of a systemic involvement of IL-33 in allergic contact dermatitis. PMID: 26357000
- crucial requirements for IL-31 signaling and its counter-regulation by SOCS3 PMID: 26306032
- IL-31 expression in allergic rhinitis aggravated and amplified Th2 inflammation as well as mucin production PMID: 25285475
- The IL-31 serum level was significantly higher in cutaneous T-cell lymphoma patients than in the control group but there were no positive correlation between IL-31 serum level and pruritus. PMID: 25176053
- IL-31 is overexpressed in the lesional skin of LP but its expression does not correlate with intensity of pruritus. PMID: 25756056
- IL-31 was increased after IVIG treatment in patients with KD and was significantly associated with CAL formation. PMID: 25122210
- Case Report: sporadic lichen amyloidosis with high expression of Il31. PMID: 24573820
- The results of this study suggest that the severity of atopic dermatitis in a Polish population is associated with some specific haplotypes of the IL-31 gene and renew questions concerning the role of IL-31 in pruritus in atopic dermatitis. PMID: 25534405
- enhanced Th2 cytokine levels was correlated with IL-31 expression in NPs and provide a possible explanation for IL-31's regulatory role in the pathogenesis of NPs. PMID: 24515918
- the results suggest that IL-31 may be a candidate gene associated with the pathogenesis of rheumatoid arthritis PMID: 25572240
- The interleukin IL-31/IL-31receptor axis contributes to tumor growth in human follicular lymphoma. PMID: 25283844
- TARC and interleukin-31 may be biomarkers for adult atopic dermatitis PMID: 24984931
- IL-31 may play an important role in the pathophysiology of uremic pruritus. PMID: 25270263
- IL-31-positive cells were observed as mononuclear infiltrating cells and as CD11b co-expressing cells in severe atopic dermatitis samples. PMID: 24667097
- Data show that STAT6 and NF-kappaB are central players in mediating IL-31 expression induced by IL-4/IL-33. PMID: 24943220
- EGFR-TK inhibitors could cause keratinocytes injury, the release of IL-33 and the consequent interaction with its receptor on mast cells, that induces the secretion of several factors capable to cause skin manifestations, included IL-31 PMID: 23794184
- IL-31 seems to be another sweat stimulator. PMID: 23874436
- CD4+CD26- malignant cells specifically produce IL-31 and clinical resolution of pruritus correlates with decreased IL-31 levels in the circulation PMID: 23698099
- IL-31 and IL-31RA are upregulated in patients with allergic rhinitis, and induce MUC5AC gene expression in human airway epithelial cells. PMID: 23392388
- IL-31 induces pro-inflammatory effects in activated human macrophages via STAT-1 and 5 phosphorylation. Interleukin-31-induced ERK 1/2 activation contributes to the underlying mechanism of Th1 cytokine IL-12 suppression in macrophages. PMID: 23621408
- Il-31 is not a TH2 cytokine in the classical sense but is likely to be expressed by a number of cells in an allergic situation in which IL-4 is present and possibly contribute to the allergic reaction. PMID: 23694808
- hypothesize that an altered regulation of IL-31 gene expression influence clinical course of AD. The available published data and our results lend support to an important role of IL-31 gene polymorphism in AD pathogenesis PMID: 22827739
- IL-31-631 T>G polymorphism was significantly associated with IL-31 blood level but not with disease susceptibility. PMID: 21952721
- T cells in chronic atopic dermatitis (AD) skin produce IL-31 and AD lesions contain increased levels of these IL-31-producing T cells. PMID: 22621183
- IL-31 serum levels correlate with the SCORAD score, sleeplessness, and Th2 cytokines including IL-4 and IL-13, in sixty children with the extrinsic type of atopic dermatitis. PMID: 22509760
- IL-31-specific activation of dendritic cells may be part of a positive feedback loop driving the progression of inflammatory skin diseases. PMID: 22539792
- Distinct SPINK5 and IL-31 gene variants (SNPs) were associated with the development of atopic eczema and non-atopic hand dermatitis in Taiwanese nurses. PMID: 22017185
顯示更多
收起更多
-
亞細胞定位:Secreted.
-
組織特異性:Detected at low levels in testis, bone marrow, skeletal muscle, kidney, colon, thymus, small intestine and trachea.
-
數據庫鏈接:
Most popular with customers
-
-
Phospho-YAP1 (S127) Recombinant Monoclonal Antibody
Applications: ELISA, WB, IHC
Species Reactivity: Human
-
-
-
-
-
-